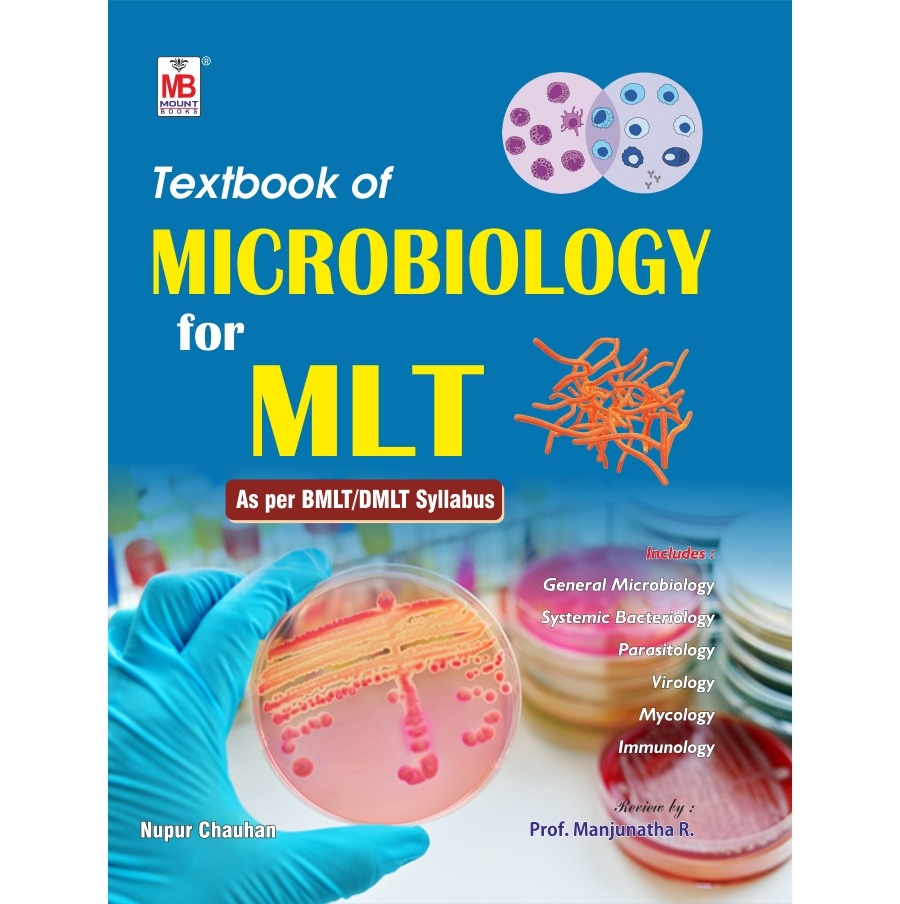

r

Textbook of Microbiology for MLT
Textbook of Microbiology for MLT offers a comprehensive and detailed exploration of microbiological principles essential for Medical...
Read More
Author :
Nupur Chauhan
Availability:
In stock
- Rs. 480.00
Rs. 400.00- Rs. 480.00
- Unit price
- per
Save Rs. -80.00
Please hurry! Only 100 left in stock
10 customers are viewing this product
Subtotal:
Rs. 480.00
Couldn't load pickup availability
Shipping Charges
Prepaid Orders Below ₹699 – ₹40 Delivery Charge
Cash on Delivery Charge – ₹100 (₹40 Delivery + ₹60 COD Fee)
Easy Replacement
Return/Replacement Validity: Only within 48 hours of delivery
Related Products
Recently Viewed Products
- Choosing a selection results in a full page refresh.


![PBBSc Nursing Second Year Question Banks [Combo Set of 5 Books]](http://mountbooks.in/cdn/shop/files/WhatsAppImage2025-06-19at18.09.41_29_165x.jpg?v=1750352351)
![B.Sc. Nursing Semester-V QB (Set of 2 Books) [As per New INC Syllabus]](http://mountbooks.in/cdn/shop/files/SemV-website-2_165x.jpg?v=1749805709)


